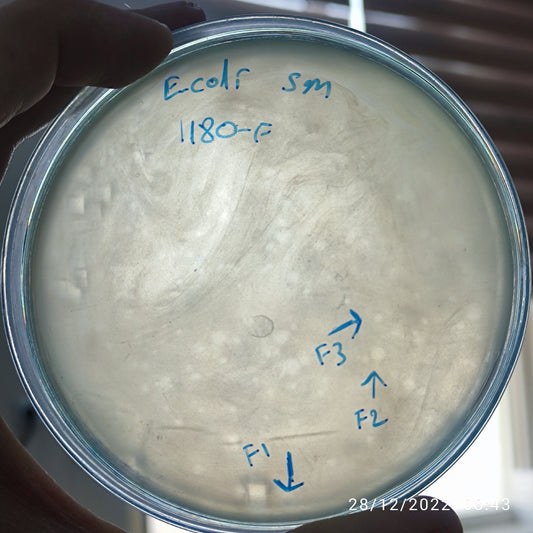
Escherichia coli bacteriophage 101180F
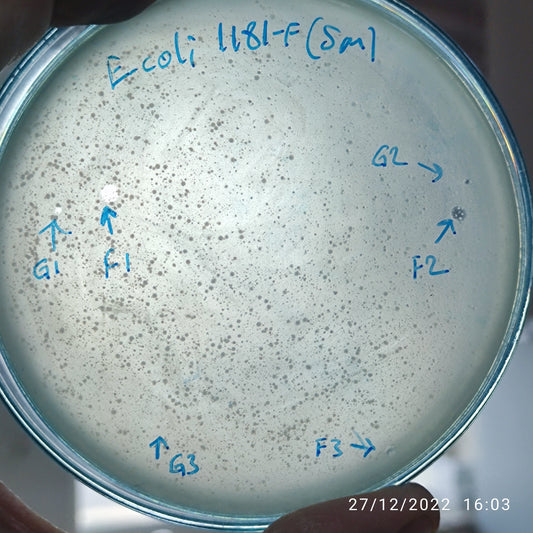
Escherichia coli bacteriophage 101181F
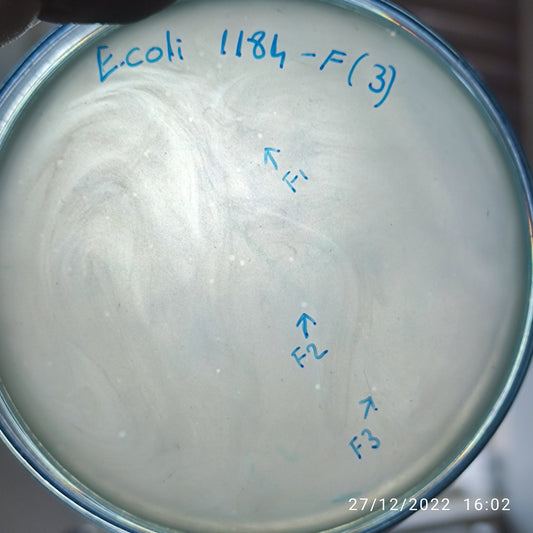
Escherichia coli bacteriophage 101184F
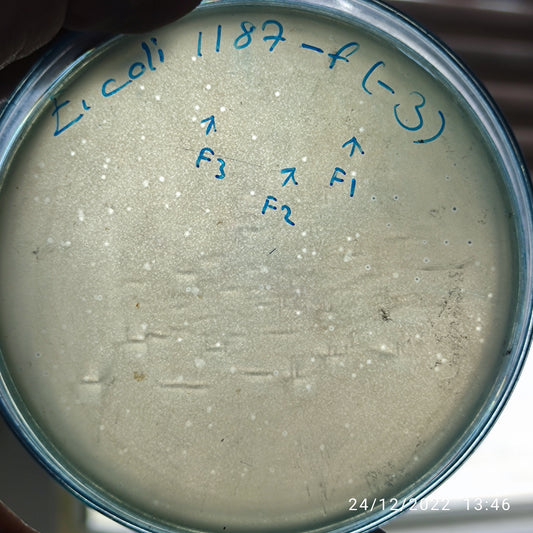
Escherichia coli bacteriophage 101187F
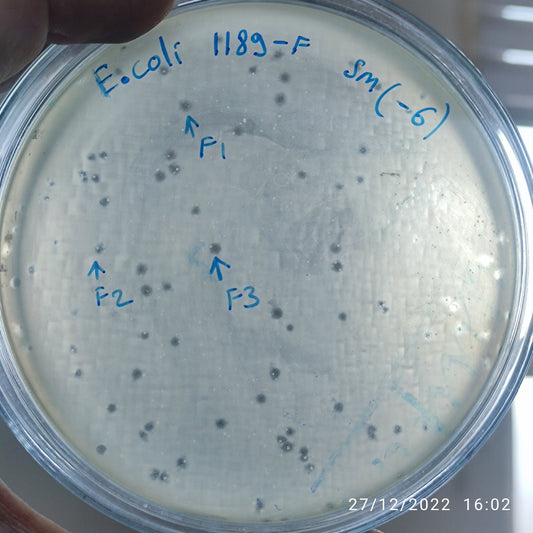
Escherichia coli bacteriophage 101189F
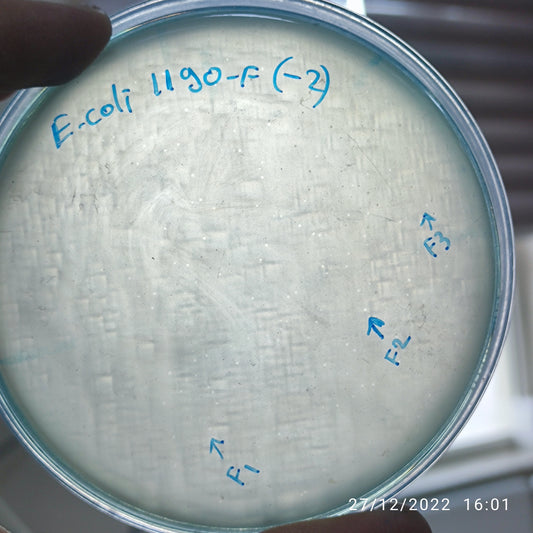
Escherichia coli bacteriophage 101190F
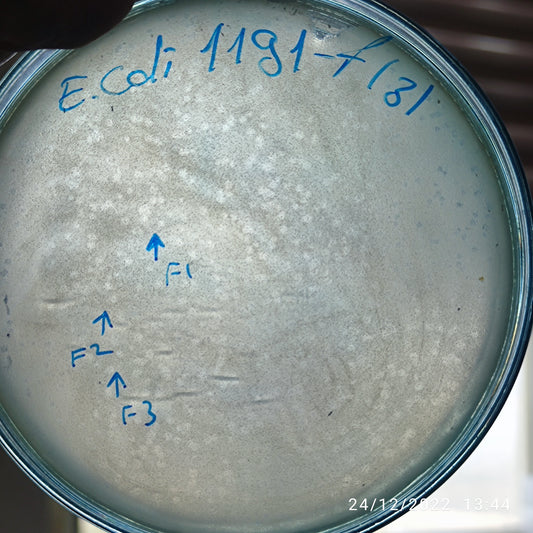
Escherichia coli bacteriophage 101191F
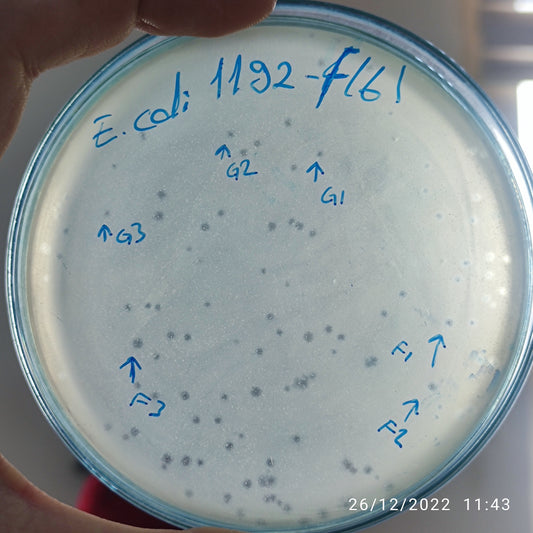
Escherichia coli bacteriophage 101192G

-
Escherichia coli bacteriophage 101180F
Regular price $500.00 USDRegular priceUnit price per -
Escherichia coli bacteriophage 101181F
Regular price $500.00 USDRegular priceUnit price per -
Escherichia coli bacteriophage 101181G
Regular price $500.00 USDRegular priceUnit price per -
Escherichia coli bacteriophage 101184F
Regular price $500.00 USDRegular priceUnit price per -
Escherichia coli bacteriophage 101185F
Regular price $650.00 USDRegular priceUnit price per -
Escherichia coli bacteriophage 101185G
Regular price $500.00 USDRegular priceUnit price per -
Escherichia coli bacteriophage 101187F
Regular price $500.00 USDRegular priceUnit price per -
Escherichia coli bacteriophage 101188F
Regular price $500.00 USDRegular priceUnit price per -
Escherichia coli bacteriophage 101188G
Regular price $500.00 USDRegular priceUnit price per -
Escherichia coli bacteriophage 101189F
Regular price $600.00 USDRegular priceUnit price per -
Escherichia coli bacteriophage 101190F
Regular price $500.00 USDRegular priceUnit price per -
Escherichia coli bacteriophage 101191F
Regular price $500.00 USDRegular priceUnit price per -
Escherichia coli bacteriophage 101192F
Regular price $0.00 USDRegular priceUnit price per$500.00 USDSale price $0.00 USDSale -
Escherichia coli bacteriophage 101192G
Regular price $500.00 USDRegular priceUnit price per -
Escherichia coli bacteriophage 101193F
Regular price $500.00 USDRegular priceUnit price per -
Escherichia coli bacteriophage 101194F
Regular price $500.00 USDRegular priceUnit price per